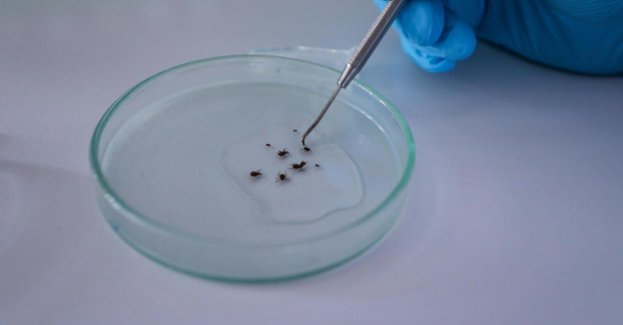

Alicja Węgorzewska: Zapadło sześć wyroków dotyczących kłamstw medialnych na mój temat. Ktoś chciał zniszczyć 30 lat mojej pracy
W zeszłym roku ukazały się trzy artykuły, taki festiwal generalnie zniszczenia człowieka, jego dotychczasowego dorobku, jego pracy. Było to dosyć zaskakujące, gdyż prowadzę Warszawską Operę Kameralną od 2016 roku i nigdy, przenigdy nie były składane na mnie żadne skargi, ani tutaj wewnętrznie, ani do organizatora, do samorządu województwa, ani do innych instytucji, do których można by było złożyć jakąkolwiek skargę na dyrektora, a przecież wiemy, że różni dyrektorzy różnych instytucji kultury mają takie problemy w kraju – mówi agencji Newseria Alicja Węgorzewska.
W artykule zatytułowanym „Straszny dwór" pojawiły się m.in. oskarżenia o mobbing, brak zespołowej atmosfery i trudne warunki pracy, które mają być przyczyną problemów natury psychicznej podwładnych. W publikacji cytowano anonimowe wypowiedzi pracowników Warszawskiej Opery Kameralnej, którzy skarżyli się chociażby na apodyktyczny charakter szefowej, podkreślając, że za kulisami WOK „panuje chaos, a życie zawodowe podporządkowane jest kaprysom dyrekcji". Alicja Węgorzewska była zbulwersowana zarzutami, jakie padły pod jej adresem.
Te artykuły przedstawiały sytuacje niebyłe w sposób obciążający mnie winą. Przykre, że człowiek 30 lat pracuje, tworzy swoją przestrzeń artystyczną, swoje nazwisko i ktoś myśli, że wystarczą trzy artykuły, żeby takiego człowieka po prostu zniszczyć w sposób dosyć nachalny, bo oprócz tych publikacji stworzono fałszywy anonimowy „list pracowników”, gdzie żadna osoba wymieniona, bo nie podpisana na tym piśmie, nie jest obecnym pracownikiem WOK i rozsyłanie tego do 77 instytucji w kraju. Cóż, brakuje słów na takie działania. Motyw jest prosty, motyw jest taki, żebym przestała być dyrektorem instytucji kultury i żeby ktoś inny mógł zająć moje stanowisko – mówi.
Alicja Węgorzewska zwróciła się do redaktorów naczelnych Newsweek Polska oraz serwisu newsweek.pl z wnioskiem o opublikowanie sześciu sprostowań. Tak się jednak nie stało, dlatego też do Sądu Okręgowego w Warszawie trafiło sześć pozwów w tej sprawie. W okresie od 26 września do 8 października zapadło sześć wyroków nakazujących opublikowanie sprostowania.
Było to sześć wyroków korzystnych dla mnie, o opublikowanie sprostowań tych kłamstw, o których pisał „Newsweek” rok temu. Dam tylko takie przykłady, że nieprawdą jest, że oficjalne biletowane koncerty zmieniają się w prywatne imprezy, czyli że używam środków publicznych do prywatnych celów, nieprawdą jest, że zarabiałam dodatkowe środki za koncerty na Mazowszu, że tworzyłam jakieś kampanie polityczne, nieprawda, że krzyczę na ludzi, nieprawda, że pracownik zmarł z powodów związanych z operą, że karetki przyjeżdżają z powodu związanego ze stresem. To wszystko jest ujęte w tych sześciu wyrokach, które mam nadzieję staną się prawomocne – mówi.
Dyrektor WOK-u wierzy, że wyroki te zostaną utrzymane w mocy przez sąd drugiej instancji i opinia publiczna będzie miała możliwość zapoznania się z treścią poszczególnych sprostowań opublikowanych właśnie w Newsweek Polska i serwisie newsweek.pl.
Kropką nad i jest tutaj przywrócenie przez sąd karny postępowania przeciw panu Konradowi Wojciechowskiemu. Toczy się również postępowanie karne przeciwko panu Jakubowi Korusowi, gdyż nie można, jak stwierdził sąd, przedstawienie ujemnej opinii w sposób złośliwy i tendencyjny, w niedopuszczalnej formie wykracza poza granice ochrony określonej przez art. 41 prawa prasowego, stanowiąc czyn zabroniony przez prawo karne. Więc wkroczyliśmy tutaj nawet w przestrzenie prawa karnego. Sąd Okręgowy uchylił wyrok Sądu Rejonowego i ta sprawa również będzie rozpatrywana – mówi.
W wywiadzie dla agencji Newseria Lifestyle Alicja Węgorzewska podsumowała 2024 rok jako czas pełen wyzwań, ale i spektakularnych sukcesów. Prezentowany przez Warszawską Operę Kameralną repertuar przyciągnął bowiem nawet najbardziej wymagających melomanów i miłośników teatru. Dyrektor WOK podkreśla, że drzemie w niej ogromny potencjał twórczy i wraz ze swoimi zaangażowanymi pracownikami udaje jej się stworzyć wyjątkowe projekty, które szybko zdobywają popularność. To wszystko nie byłoby możliwe bez ciężkiej pracy i determinacji wielu osób. Jednocześnie zapewnia, że w instytucji przez nią kierowanej nie ma i nigdy nie było mobbingu.
Oczekiwanie wykonywania pracy od ludzi, a instytucja kultury jest bardzo wymagającym miejscem pracy, bo tutaj wszystko jest w przebiegu stricte czasowym, to nie jest mobbing. Kurtyna idzie do góry o 19.00 i wszystko musi po prostu być przygotowane, nie ma żadnej przestrzeni na zaniedbania. I to jest największa trudność, bo pracownicy chcą pracować w prestiżowym miejscu pracy, bo takim jest opera, a potem stwierdzają: no cóż, próby 10.00-14.00, ale potem 18.00-22.00, a potem dyżury w weekendy, bo są spektakle, bo są koncerty, bo są wyjazdy i okazuje się, że to prestiżowe miejsce pracy jest cudowne, tylko nie można, albo nie chce się mu poświęcać tego czasu, który jest tutaj wymagany – mówi.
Śpiewaczka podkreśla, że ta cała sytuacja negatywnie odbiła się na jej życiu prywatnym i zawodowym. Kosztowała ją wiele nerwów i energii. Dlatego do końca zamierza walczyć o swoje dobre imię.
Ta sytuacja zabrała mi dużo czasu, który przeznaczyłabym dla rodziny, dla przyjaciół, dla swoich spraw, dla rozwoju artystycznego, a tak to musiałam stracić ten czas na czytanie tych artykułów, na konstruowanie oświadczeń i sprostowań. Ale nie miałam innego wyjścia, trzeba się bronić – dodaje.
Źródło: Newseria